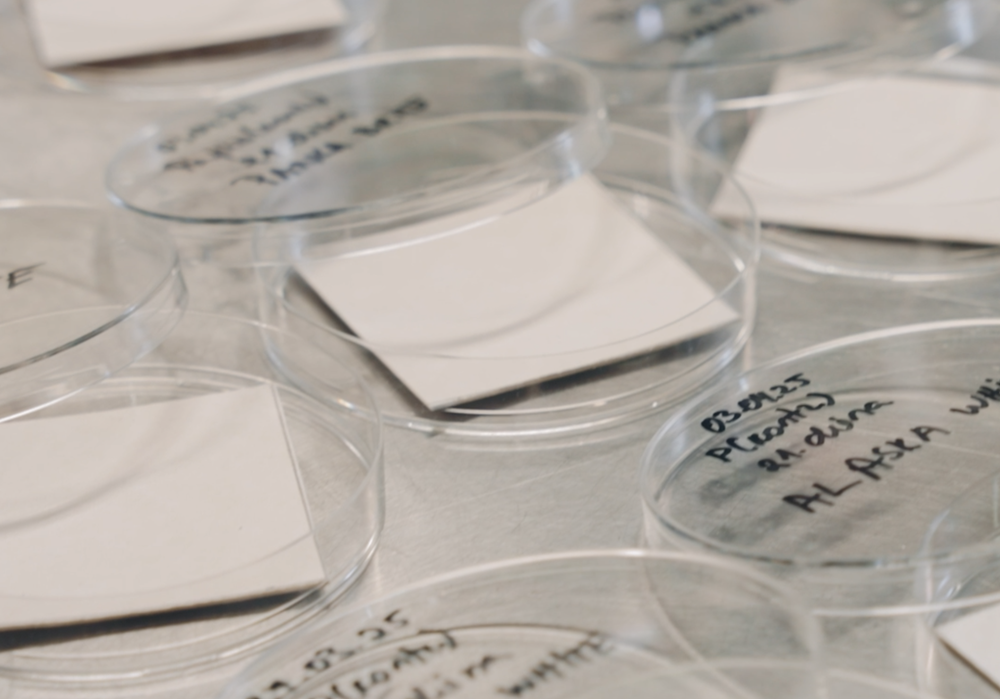

"Zinātne palīdz stiprināt Latvijas pārtikas ķēdes drošību un līdz ar to mūsu valsts patstāvību un neatkarību no ārējiem faktoriem. Pēdējie gadi parādīja dažādu apstākļu – pandēmijas, kara, enerģētiskās krīzes, klimata pārmaiņu – ietekmi uz piegādes ķēžu stabilitāti. “Ja Latvija spēj ražot un uzglabāt savu pārtiku droši un neatkarīgi, mēs spējam pastāvēt arī krīzes situācijās,” saka Dārzkopības institūta vadošā pētniece Dalija Segliņa, kura vada Valsts pētījumu programmas “Vietējo resursu izpēte un ilgtspējīga izmantošana Latvijas attīstībai 2023–2025” projektu “GreenAgroRes”.
Viņa mūs vārda tiešā nozīmē izved cauri visai pārtikas ķēdei – no sēklas, dārza līdz veikalam un galdam. Dalija ir viena no vadošajām pētniecēm zinātnieku komandā, kas strādā pie ilgtspējīgiem risinājumiem vietējo pārtikas resursu ieguvei kvalitatīvas produkcijas ražošanai, iekļaujoties Eiropas Savienības noteiktajos Zaļā kursa mērķos.
Projekts “GreenAgroRes” palīdz Latvijai sasniegt Eiropas Zaļā kursa mērķus: mazāk pesticīdu, vairāk bioloģiskās lauksaimniecības, tīrāki ūdeņi un veselīgāka zeme. Tas nozīmē — drošāku pārtiku, tīrāku vidi un stiprāku valsti. Eiropas Zaļais kurss vērsts uz pārmaiņām visā Eiropā, un Latvijas zinātnieki dod savu ieguldījumu, veicot pētījumus laboratorijās, dārzos un laukos, ezeros un lauksaimniecības dzīvnieku novietnēs.
Pētnieki no Latvijas Biozinātņu un tehnoloģiju universitātes, Agroresursu un ekonomikas institūta, Dārzkopības institūta un BIOR sadarbojas, lai no lauka līdz galdam izveidotu drošu un pilnvērtīgu pārtikas ķēdi. “Zaļais kurss nav tikai par dabu un tās interesēm, tas strādā arī cilvēku labā”, uzsver Dalija Segliņa. “Vietēja, kvalitatīva un droša pārtika ir nozīmīgs priekšnoteikums valsts ilgtspējai”.

Mazāk ķīmijas, vairāk saules – gudrā dārzkopība
Dārzkopības institūtā Dobelē pētnieki pārskata ābeļu audzēšanas principus, lai iegūtu tīrāku un bagātīgāku ražu. “Mēs sargājam ābolu no kaitēkļiem un slimībām, bet vēlamies lietot mazāk ķīmijas,” skaidro Dalija Segliņa. “Pētījumos eksperimentējam ar vainagu formām, veidojam šaurākas lapotnes, lai saules stari un vējš varētu vieglāk piekļūt, nožāvēt augļus un lapas. Tad slimības izplatās mazāk, āboli ir vieglāk novācami, tie mazāk bojājas un ir ilgāk uzglabājami.” Nākotne ir augstas precizitātes dārzkopībai, kur zinātnieki ir vienlaikus agronomi, un, izmantojot dronus, sensorus un kameras, spēj attālināti novērtēt dārzu veselību. Iegūto datu analīze ļauj precīzi izvēlēties dārza kopšanas metodes, nepieciešamo mitruma, mēslošanas līdzekļu un pesticīdu apjomu. “Tā mēs varam samazināt pesticīdu lietošanu, resursu patēriņu un izmaksas. Rezultātā iegūstam drošāku vietējo pārtiku un mazāku atkarību no importa,” stāsta pētniece.

Zinātne, kas skatās arī ūdenī
Pētnieki šajā projektā rūpējas par vēl vienu būtisku pārtikas drošības posmu – ūdens un zivju kvalitāti. Zivis ir nozīmīga pilnvērtīga uztura produktu grupa. BIOR Zivju resursu departamenta un ķīmijas eksperti analizē zivis no četriem Latvijas lielākajiem ezeriem, lai pārliecinātos, ka tās ir drošas lietošanai uzturā un sniedz cilvēkam labumu. Šie pētījumi ļauj saprast, kā civilizācijas radītās sekas un klimata pārmaiņas ietekmē zivju kvalitāti un līdz ar to arī cilvēku veselību. Latvijas ezeru vērtīgo zivju krājumi papildina un bagātina vietējās pārtikas resursus.

Ābols pārtop šķīvī
Pārtikas produktu ražošanas procesā rodas blakusprodukti, kas var kļūt par izejvielu citiem produktiem. Tāpēc nākamais solis gudrā saimniekošanā un drošas pārtikas ķēdē ir rast risinājumus to lietderīgai izmantošanai. Zinātnieku laboratorijās blakusprodukti iegūst jaunu dzīvi. “No klijām un augļu spiedpaliekām mēs izstrādājam dabīgus, bioloģiski noārdāmus un arī ēdamus traukus” stāsta Dalija Segliņa. “Lai arī tie satur daudz šķiedrvielu, kas ir noderīgi cilvēku veselībai, taču galvenais ieguvums ir radīt jaunu produktu, veicinot bezatlikumu tehnoloģiju ieviešanu”. Šāda pieeja ir aprites ekonomikas stratēģija, nevis modes tendence. Ja mēs spējam izmantot to, kas mums jau ir, mēs vairojam resursu noturēšanu ekonomikā, vienlaikus mazinot atkritumu apjomu un ietekmi uz vidi.
No sūkalām – proteīns nākotnei
Piena pārstrādes blakusprodukti, kas vairumā gadījumu netiek izmantoti, arī var kļūt par vērtīgu resursu. “No siera ražošanas atlikuma – sūkalām – mēs iegūstam augstvērtīgas olbaltumvielas, ko var izmantot pārtikā, sporta uzturā vai medicīnā,” skaidro pētniece. “Tas arī ir stāsts par produktu ar pievienoto vērtību radīšanu – mazāk atkritumu, vairāk resursu Latvijā.” Lielākais izaicinājums ir šo procesu komercializēt. “Atgūstamais proteīna daudzums no sūkalām nav liels, tāpēc jāatrod veids, kā padarīt šo procesu ekonomiski izdevīgu un piemērotu ražošanai lielākos apjomos. Tas ir vēl viens uzdevums, ko risina zinātnieki”.

Droša un videi draudzīga pārtikas uzglabāšana
Vienreizlietojamie plastmasas izstrādājumi pasaulē ir kļuvuši par milzīgu problēmu. Plastmasas piesārņojums nonāk vidē, ūdeņos un pat pārtikā. Tomēr pilnīga atteikšanās, galvenokārt no pārtikas produktu iepakojuma, nav iespējama, jo pārtika bez aizsardzības ātrāk bojājas un kļūst nedroša lietošanai uzturā.
“Mēs strādājam pie iepakojumu materiālu izveides, kas ir droši gan cilvēkiem, gan dabai un to ražošana būtu ekonomiski izdevīga”, skaidro Dalija Segliņa. “Testējam bioloģiski noārdāmus pārklājumus un lakas, kas spēj aizstāt plastmasas slāni, vienlaikus saglabājot gaismas caurlaidību un produktu drošumu. Eksperimentu rezultāti rāda, ka izvēlētie materiāli pārtikas aizsardzības funkcijas veic pat labāk, nekā plastmasa”. “Ar šiem jaunajiem materiāliem mēs varam būtiski pagarināt pārtikas uzglabāšanas laiku, mazinot plastmasas izmantošanu iepakojumā,” piebilst pētniece.
Valsts pētījumu programmas projekts “GreenAgroRes” apvieno Latvijas zinātniekus, lai radītu ilgtspējīgus risinājumus Latvijas dabas resursu gudrai izmantošanai un atbalstītu Eiropas Zaļā kursa mērķus. Pētījumos tiek meklēti veidi, kā ražot kvalitatīvu un konkurētspējīgu pārtiku videi draudzīgā veidā, un kādi iepakojumi ir visefektīvākie pārtikas drošai uzglabāšanai ilgtermiņā.
Pētnieki izvērtē dažādu risinājumu ietekmi uz sabiedrību un ekonomiku. Īpaša uzmanība tiek pievērsta pesticīdu lietošanas mazināšanai graudkopībā un dārzkopībā, lauksaimniecības dzīvnieku veselības drošībai, pievienotās vērtības pārtikas radīšanai un aprites ekonomikas iespējām, kā izejvielu izmantojot pārtikas pārstrādes blakusproduktus. Zinātnieki, noslēdzot projektu, ir radījuši būtiskus risinājumus, kas veicina Latvijas lauksaimniecības, bioekonomikas un vides ilgtspējīgu attīstību. Projektā ir paveikts plašs pētnieciskais un praktiskais darbs, kas sniedz jaunas zināšanas, inovācijas un priekšlikumus nākotnes attīstības politikai.
Zinātnieku komanda projekta laikā:
- izstrādājusi videi draudzīgus risinājumus vietējās lauksaimniecības produkcijas ražošanas attīstībai, integrējot viedās tehnoloģijas un ilgtspējīgas ražošanas pieejas;
- ieguvusi jaunas zināšanas un sagatavojusi priekšlikumus ilgtspējīgas bioekonomikas un lauku telpas attīstībai, sekmējot Eiropas zaļā kursa mērķu sasniegšanu;
- izstrādājusi risinājumus lauksaimniecības dzīvnieku slimību un citu faktoru radītā apdraudējuma samazināšanai sabiedrības veselībai un videi, ievērojot principu “Viena veselība”;
- radījusi jaunus produktus, tehnoloģijas un tehnoloģiskos risinājumus, kas veicina augstas pievienotās vērtības pārtikas produktu ražošanu un videi draudzīgāku iepakojumu izmantošanu;
- paplašinājusi zināšanas par iekšzemes ūdeņu un zivju resursu ilgtspējīgu izmantošanu, izmantojot integrētas pieejas, kas nodrošina dabas resursu saglabāšanu nākamajām paaudzēm;
- sagatavojusi deviņus ziņojumus – rekomendācijas un vadlīnijas, kuros ietverti rīcībpolitikas ieteikumi, balstīti uz zinātniskajiem pētījumiem un pierādījumos pamatotiem rezultātiem.









































































































































